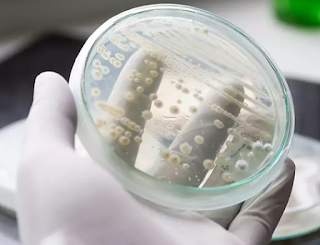
CANDIDA AURIS, UN PATÓGENO EMERGENTE CANDIDA AURIS, UN PATÓGENO EMERGENTE

En los últimos días los medios de comunicación alrededor del mundo nos han informado de la presencia de un super microorganismo llamado ‘Candida auris’
Auris proviene del latín “oído”. Este es un hongo que se ha convertido en una verdadera amenaza global por su gran capacidad de diseminación y de resistir a los medicamentos antifúngicos disponibles en la actualidad.El primer reporte de C. auris se lo realizó a partir de una secreción de oído de una paciente en Japón en el año 2009 (1). A partir de ese hallazgo, este microorganismo ha sido reportado en varios países alrededor del mundo y de las Américas como: Venezuela, Colombia, Panamá, y Estados Unidos. Lo más preocupante es que muchos de los aislamientos se encuentran altamente relacionados dentro de un país o región, pero son sumamente distintos entre continentes.Un estimado de la incidencia anual global de las infecciones producidas por este hongo sugiere alrededor de 400.000 casos, con hasta un 40 % de mortalidad hospitalaria con base en información del Consejo de Estado y Epidemiólogos Territoriales (CSTE), de EE.UU. La mayoría de los casos en Estados Unidos en el último reporte por el Centers for Disease Control and Prevention (CDC) de Atlanta, indica que, hasta el 28 de febrero del 2019, 587 son casos confirmados y en 1056 pacientes se encontró colonización por el microorganismo. Las ciudades con mayor reporte de C. auris son: Nueva York, Nueva Jersey, Chicago. Este microorganismo es un hongo emergente que puede causar infecciones graves en pacientes hospitalizados e incluso la muerte, especialmente en pacientes con un sistema inmunitario débil como ancianos, recién nacidos, diabéticos, oncológicos, VIH/Sida y aquellos con días de estancia prolongada.Al detectar el microorganismo es fundamental tomar todas las medidas de aislamiento de contacto, debido a que si no existe un control adecuado este hongo puede contaminar el ambiente hospitalario extendiéndose a unidades de cuidado intensivo, quirófanos, áreas de neonatología, entre otros. Es muy importante frente a su hallazgo reforzar todas las medidas multimodales, entre ellas el lavado de manos, procesos de limpieza y desinfección de alto nivel de las diferentes áreas para brindar ambientes seguros y saludables a los pacientes y personal de salud.¿Existe la presencia de C. auris en el Ecuador?Hasta la presente fecha no existen reportes oficiales de la presencia de C. auris en el Ecuador. Debemos estar alerta y sospechar de la presencia de este microorganismo ya que C. auris puede identificarse erróneamente con microrganismos similares como C haemulonii, Saccharomyces cerevisiae o Candida spp y esto dependerá de los métodos y sistemas de detección disponibles. Para ello es necesario seguir recomendaciones nacionales e internacionales para una correcta identificación y notificación oportuna del microorganismo.Es necesario estar preparados frente al hallazgo de estos patógenos emergentes en el país, desde el punto de vista, clínico, epidemiológico y de laboratorio y así contener su diseminación en nuestros hospitales.Hoy es el momento de actuar y la mejor arma del ser humano es la ciencia, que se ha convertido en el nuevo futuro de la medicina, labrando un camino de esperanza para el mundo con tecnología de alto nivel que permite controlar este tipo de patógenos emergentes.360Life con su innovador robot LightStrike utiliza rayos ultravioletas para eliminar todo tipo de gérmenes infecciosos presentes en los hospitales, reduciendo así la tasa de IAAS a nivel mundial, presentándose como una solución potencial para contribuir a la salud humana en contra de las resistentes bacterias.
